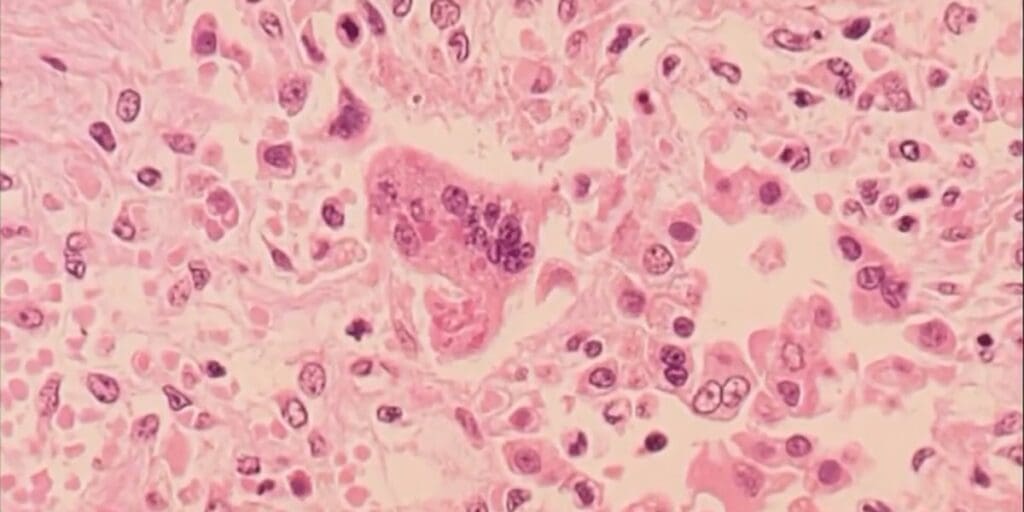

VDH warns of 2 more measles exposures in Northern Virginia
—
RICHMOND,Va.(WWBT)–TheVirginiaDepartmentofHealthisinvestigatingtwoconfirmedcasesofmeaslesthattraveledthroughNorthernVirginiathismonth.
“BothpeopleareMarylandresidentswhorecentlytraveledtogetherinternationally,”VDHsaid.“Healthofficialsarecoordinatinganefforttoidentifypeoplewhomighthavebeenexposed,includingcontactingpotentiallyexposedpassengersonspecificflights.”
VDHsaysthedates,timesandlocationsofthenewpotentialexposuresare:
DullesInternationalAirportonWednesday,March5onConcourseA,ontransportationtotheInternationalArrivalsBuildingandinthebaggageclaimareabetween8a.m.and12:30p.m.RonaldReaganNationalAirportonFriday,March14ontheTerminalShuttleBusbetweennoonand2:30p.m.WashingtonareaMetroonFriday,March14ontheYellowLineTrainfromRonaldReaganWashingtonNationalAirportstationtransferringattheL’EnfantPlazastationtotheSilverLineTrainheadingtowardtheDowntownLargostationbetween12:15p.m.and3:15p.m.
Thisisthethirdcaseofconfirmedmeas